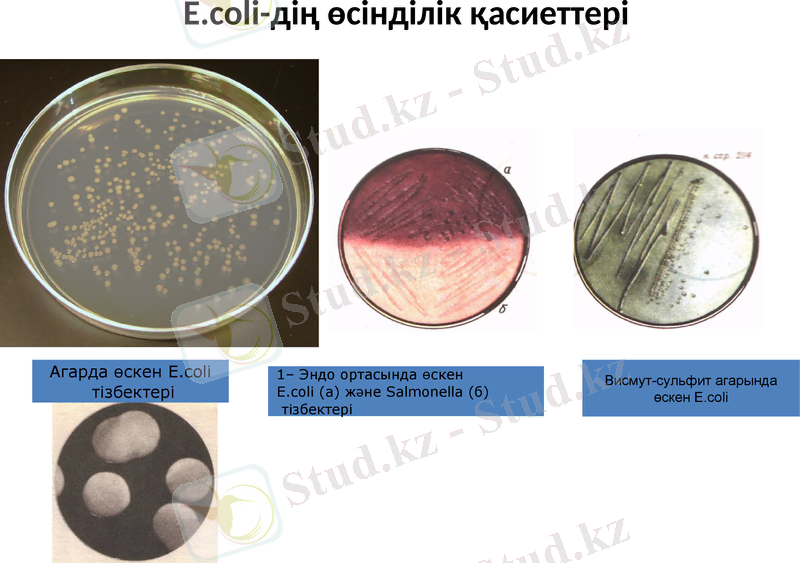
Slide 8
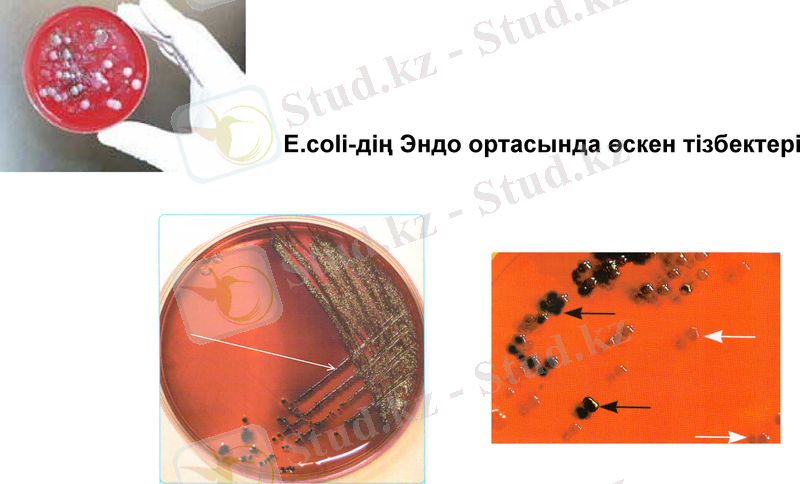
Slide 9

Колибактериозды бактериологиялық зерттеу: Escherichia coli морфологиясы, биохимиялық қасиеттері және лабораториялық диагностика



Қазақстан Республикасы Ауыл шаруашылығы министрлігі
«Қазақ ұлттық аграрлық университеті»
Ветеринария факультеті
Биологиялық қауіпсіздік кафедрасы
Колибактериозды бактериологиялық зерттеу
Алматы, 2019

Эшерихиоз немесе колибактериоз - бұл әр түрлі жануарлардың төлдері, құстар ауыратын өте жіті өтетін індеттік ауру. Диареямен, профузды іш өтумен, депрессиямен, организмнің құрғауымен, әлсіреумен және өліммен сипатталады. Ауру туа салысымен тіркеледі.
Бұл ауру ауыл шаруашылық малдарының төлдерінде (бұзау, қозы, торай, құлындарда) туылғаннан кейін 2 - 3 күннен кейін байқалатын ауру.

Морфологиялық және өсінділік қасиеттері:
Escherichia coli-өте жуан, шеттері дөңгелектенген, қысқатаяқша. Факультативті аэроб; спора және дақ түзбейді. Қозғалмалығы әр түрлі деңгейде көрсетілген; қозғалмайтын штаммдар да кездеседі. Полиморфты, әсіресе сұйық қоректік орталарда. Анилин бояуларымен жақсы боялады, Грам бойынша - теріс. Жағындыда бір талдап, жұппен немесе қысқа шынжыр түрінде орналасады.
Кез келген қоректік орталарда (pH - 7, 2 - 7, 4) оптимальды температурада 35 - 370С оңай өсіріледі. ЕПА жіңішке сызықтар бойынша өседі, алғашында көгілдір түсті мөлдір тізбектер, ал содан кейін сұр - ақ түске айналады.
Агарда тізбек түрі тегістен (S - форма) шеттері бухтатәрізді кедір бұдыр (R - форма) болады. ЕПС - пробирканың түбінде оңай бұзылатын шөгінді түзіледі. Кейбір кезде сорпа бетінде жіңішке қап түзіледі. ЕПЖ- жіп тәрізді, орта сұйылтылмаған. Сүтте өсу 1 - 4 тәуліктен кейін ұйды, кейде қыздырған кезде, лакмус сүті қызарады. Ұйылған қан сары суын сұйылтпайды.

Микроб биохимиялық қатынасы жағынан өте белсенді: көмірсуларды және көп атомды спирттер қатарын, сонымен қатар лактозаны да ыдыратады, Salmonella тобының барлық өкілдерінен ажыратылады. Индол түзуі барлық түр өзгешеліктерінде байқалмайды. Күкірт сутек және аммиак, нитраттар нитриттерді редукциялайды. Түрлі түсті дифференциялды орталар (Эндо ортасында металл тәрізді қызыл тізбектер, Левин ортасында көк немесе қара, Плоскирев ортасында қоңыр, бромкрезол ортасында жасыл тізбектер түзіледі

Бактериологиялық зерттеудің кестесі

1. Қысқа, спора түзбейді, қозғалмалы (перитрихия) немесе қозғалмайды, капсула түзеді немесе түзбейді;
2. Грам бойынша теріс боялады;
3. Глюкозаны және басқа да көмірсуларды қышқыл және газ, немесе тек қана қышқыл түзіп ферменттейді;
4. Протеолитикалық қасиеттеріне ие емес;
5. Факультативті анаэроб немесе аэробтар;
6. Кәдімгі қоректік орталарда жақсы өседі;
7. Адамдар мен жануарлардың тыныс алу және ішек жолдарында мекендейді;
8. Негізінен алиментарлы жолмен жұғады;
9. Цитохромоксидазасы болмайды;
10. Каталаза сынамасына оң;
11. Нитраттар мен нитриттерді қалпына келтіреді;
12. Хемоорганотрофтар;
13. ДНҚ Г+Ц мөлшері 39 - 59 мол%.
Enterobacteriaceae тұқымдасы үшін тән белгілер:

Эшерихиоз қоздырушысының морфологиясы
Ішек таяқшасының электронограммасы
Жгутиктері
Пилилер
Бактериофагтар
E. сoli морфологиясы
(микроскоптық көрінісі)
E. coli-дің өсінділік қасиеттері
Агарда өскен E. сoli
тізбектері
1- Эндо ортасында өскен
E. coli (а) және Salmonella (б)
тізбектері
Висмут-сульфит агарында
өскен E. coli
E. coli-дің Эндо ортасында өскен тізбектері

E. coli биохимиялық қасиеттері
Негізгі биохимиялық тестер
E. coli
S. choleraesuis
1. Көмірсулардың ферментациясы:
Глюкоза
ҚГ
Қ / ҚГ
Лактоза
ҚГ
-
Мальтоза
ҚГ
Қ / ҚГ
Маннит
КГ
Қ / ҚГ
Сахароза
+ ҚГ /-
-
Дульцит
ҚГ /-
+
Арабиноза
ҚГ
+/-
Галактоза
ҚГ
-
2. Нитраттарды нитрит
терге айналдыру
+
+
3. H2S түзілуі
-
+
4. Индол түзілу
+
-
5. Цитратты аш агардағы өсуі
-
+
6. Желатинде сұйылтуы
-
-
7. Сүт
Ұйып қалу
ҚГ - қышқыл, газ түзілуі; Қ - қышқыл түзілуі

E. coli-дің ферментативтік қасиеттері
E. сoli Гисс ортасына жасалған себінділер

E. сoli қанды агардағы себінділері:
1 - гемолитикалық штамдары;
2- гемолитикалық қасиеттері жоқ штамдары
1
2

Е. coli-дің антигендік құрылымы
Е. coli бактерияларында липополисахаридты (О-Аг), жіпшелі, құрамы белок (Н-Аг), капсулды полисахаридты (К-Аг) антигендер анықталған (араб цифрларымен белгіленеді) .
0-Аг 173, К-Аг 170 және Н-Аг 60 сероварларына бөлініп алынған.

Патогенді Escherichia сoli-дің жіктелуі
Категориясы
Серотоптары
Сероварианттар
Энтеротоксигенді E. coli
О6, 08, 015, 020, 025, 027, 063, 078, 080, 0, 85, 0115, 0128 ас, 0139, 0148, 0153, 0159, 0167
06:Н16, 08:Н9, 011:Н27, 015:Н11, 020:Н-, 025:Н-, 027:Н7, 063, 078:Н11, О128:Н7, О148:Н28, О149:Н10, 0159:Н20, 0167
Энтероинвазиялық E. coli
028 ас, 029, 0124, 0136, 0143, 0144, 0152, 0164, 0167.
028 ас:Н-, О112ас:Н-, 0124:Н32, 0136:Н-, 0159:Н2, 0164, 0167:Н4, 0167:Н5, 0124:Н30.
Энтеропатогенді E. coli
Класс 1. 055, -86, 0111, 0119, 0125, 0126, 0127, 0128 аb, 0142
Класс 2. 018, 044, 0112, 0114
018ас:Н7, 020 аb:Н26, 026:Н-, 026:Н-, 044:Н34, 055:Н-, 055:Н6, 055:Н7, 086а:Н, 086а:н34, 0111 аb:Н-, 0111 аb:Н2, 0111 аb:Н12, 0114:Н10, 0114:Н32, 0119:Н-, 0119:Н6, 0125ас:Н21, 0126:Н-, 0126:Н7, 0127:Н-, 0127:Н9, 0127:Н21, 0128 аb:Н2, 0128 ас:Н12, 0142:Н6, 0158:Н23, 0159
Энтерогеморрагиялық E. coli
0157, 026, 0111, 0145
0157:Н7

E. coli бактерияларының ПАТОГЕНДІ ФАКТОРЛАРЫ:
1. АДГЕЗИЯ ЖӘНЕ ТІЗБЕКТЕР ФАКТОРЛАРЫ арқылы мембрана торшаларының рецепторларын танып, оларға жабысып және торшаларды тізбектейді. Плазма гендерімен кодталады. Оларға жататын:
- фимбриялар;
- энтеропатогенді және энтерогеморрагиялық эшерихиоз түрлерінде табылған сыртқы мембрананың белогі - интимин;
- Липополисахаридтер.
2. ИНВАЗИЯ ФАКТОРЛАРЫ арқылы E. coli ішектің эпителий торшаларына еніп, көбейіп және оларды ыдыратады. Бұл фактор E. coli энтероинвазивті түрлеріне тән.
- сыртқы мембрана белогі.
3. ЭКЗОТОКСИНДЕРді E. coli сыртқы ортаға (індеттелген организм) секрециялайды. Бұларға жататын:
- цитотониндер ішек торшаларындағы құрамында иондар Na+, К+, Cl, бикарбонаттар бар сұйықтардың гиперсекрециясына себепші болып, диареяның дамуына және су - тұз алмасуынның бұзылуына әкеп соғады.
- цитотоксиндер эндотелий капиллярларының және ішек қабырғаларының торшаларын ыдыратуға себепші болады.
4. ЭНДОТОКСИНДЕР - бактерия торшалары ыдырағаннан кейін босатылады, липополисахаридтер деп аталады. Олар антигендік ерекшелігін анықтайды және эндотоксикоздың себебі болып табылады.

Зардапты материал
(Өлексе тұтасымен, бауыр кесектерін өт жолдарымен, талақ, бүйрек, зақымдалған өкпе бөліктерін, он екі иелі ішек пен тоқ ішек кесінділерін, лимфа түйіндерін, жүрек қанын пипеткаға сорып алып, жілік сүйегін
Эшерихиоздің лабораториялық диагноз қою схемасы
Жағындыларды микроскоптау
(Грам, Романовский-Гимза әдістерімен бояу)
ЕПА, ЕПС және Эндо, Левин, Плоскирев
ортасына себінді жасайды
Биохимиялық қасиеттерін
зерттеу
Серологиялық типтеу
ОК-агглютинирлеуші қан
сарысуымен АР қою
Идентификациялау
Биосынама қою

БАКТЕРИОЛОГИЯЛЫҚ ЗЕРТТЕУЛЕР
№
Зерттеуге арналған материалдар:
Өлексе тұтасымен, бауыр кесектерін өт жолдарымен, талақ, бүйрек, зақымдалған өкпе бөліктерін, он екі иелі ішек пен тоқ ішек кесінділерін, лимфа түйіндерін, жүрек қанын пипеткаға сорып алып, жілік сүйегін
Бактериологиялық зерттеулер
1
Себінді жасау
ЕПА, ЕПС және Эндо, Левин, Плоскирев орталарына жүрек қанынан, паренхиматозды органдардан, өттен, ішектерден, лимфа түйіндерінен (міндетті түрде мезентериалды) және жілік сүегі (балауса емес материал кезінде міндетті түрде) егу
2
Микроскопиялық зерттеу
Жүрек қанынан, паренхиматозды мүшелерден жағындыларды дайындау (Грам, Романовский - Гимза және т. б. бояу әдістер бойынша) ; жағындыларды микроскопиялау
3
Өсіндік қасиеттерін зерттеу
18-24 сағаттан соң 370С температурада тығыз қоректік ортада өскен өсіндісін зерттейді.
4
АР көмегімен антигендік құрлымы бойынша бөлінген микроорганизмдердің патогенді топтарына жататындығын анықтау
Бұл үшін 10 лактоза оң тізбектерді тауып және шыны айнекшеде ОК - қан сары су қоспасында патогенді серотоптарды агглютиндейді.
5
Ферментативтік қасиеттерін анықтау
Гисс ортасына - көміртектер және көп атомды спирттер қосылған (лактоза, глюкоза, сахароза, дульцит, маннит, арабиноза және т. б. ), Штерн сорпасына себу, Биттера ортасы рамнозамен, сүтке, желатинаға және лакмусты сүтке себу жасайды; күкіртті сутекке, индолға сынама откізеді
6
Антигендік қасиеттерін анықтау
Топтық қан сарысуларымен АР қою
7
Патогендігін анықтау
Патогендігін анықтау үшін үш ақ тышқанға 500 ТТБ/мл дозасында жұқтырады
Бактериологиялық зерттеудің кестесі

Емі. Колибактериозбен ауырған төлді оқшаулап, емдейді. Ем кешенді
- Іс жүргізу
- Автоматтандыру, Техника
- Алғашқы әскери дайындық
- Астрономия
- Ауыл шаруашылығы
- Банк ісі
- Бизнесті бағалау
- Биология
- Бухгалтерлік іс
- Валеология
- Ветеринария
- География
- Геология, Геофизика, Геодезия
- Дін
- Ет, сүт, шарап өнімдері
- Жалпы тарих
- Жер кадастрі, Жылжымайтын мүлік
- Журналистика
- Информатика
- Кеден ісі
- Маркетинг
- Математика, Геометрия
- Медицина
- Мемлекеттік басқару
- Менеджмент
- Мұнай, Газ
- Мұрағат ісі
- Мәдениеттану
- ОБЖ (Основы безопасности жизнедеятельности)
- Педагогика
- Полиграфия
- Психология
- Салық
- Саясаттану
- Сақтандыру
- Сертификаттау, стандарттау
- Социология, Демография
- Спорт
- Статистика
- Тілтану, Филология
- Тарихи тұлғалар
- Тау-кен ісі
- Транспорт
- Туризм
- Физика
- Философия
- Халықаралық қатынастар
- Химия
- Экология, Қоршаған ортаны қорғау
- Экономика
- Экономикалық география
- Электротехника
- Қазақстан тарихы
- Қаржы
- Құрылыс
- Құқық, Криминалистика
- Әдебиет
- Өнер, музыка
- Өнеркәсіп, Өндіріс
Қазақ тілінде жазылған рефераттар, курстық жұмыстар, дипломдық жұмыстар бойынша біздің қор #1 болып табылады.



Ақпарат
Қосымша
Email: info@stud.kz